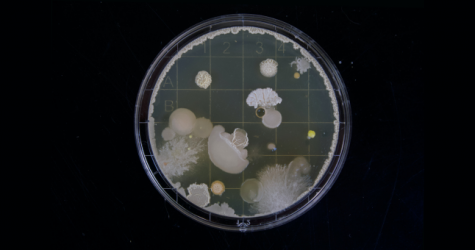
Я только спросить: тестировать вакцину от коронавируса на себе — это опасно?

Кира Найтли, Кирстен Данст и другие знаменитости, которые не сделали себе улыбку на миллион

Как ухаживать за кожей, если вы сделали пирсинг на лице

Мы узнали, сколько стоит идеальное лицо из инстаграма
 ХИТ
ХИТ
Как превратить белый жир в бурый и почему это важно
 ХИТ
ХИТ
Чем полезен вакуум для живота и как его делать